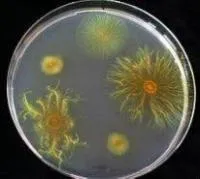

Химические реактивыв Туркестанской области
640 000 KZT
под заказ
Силикагели КСМГ КСКГ
АХК Химтрейд
Актобе
Силикагели технические марок КСМГ и КСКГ ГОСТ 3956-76 Назначение Силикагель – это стекловидные и стекловидноматовые зерна овальной или сферической формы, представляющие собой высушенный гель кремниевой кислоты пори...
Рубрика:
Реактивные жидкости

цену уточняйте
в наличии
Кислота азотная 56%
Изомер
Алматы, Шымкент
Азотная кислота - сильная одноосновная кислота. Смешивается с водой в любых соотношениях. В водных растворах она практически полностью диссоциирует на ионы. Образует с водой азеотропную смесь с концентраций 68,4 % и tкип...
цену уточняйте
в наличии
Тест на определение кислотности масла
Теплофон
Темиртау, Караганда
Тест на определение кислотности масла
Рубрика:
Индикаторы
цену уточняйте
под заказ
N-(I-Нафтил)-этилендиамин солянокислый, более 98% (уп.5 г) Sigma-Aldrich
Лаборфарма
Алматы, Астана
2-(1-нафтиламино)этиламин дигидрохлорид Код товара 2682444

1 150 KZT
за килограмм
Тиомочевина
ТОО "ALA AGRO"
Алматы
Тиомочевина (Диамид тиоугольной кислоты, Тиокарбамид) – консервант и канцероген, не имеет разрешения на применение в пищевом производстве. Химическая формула CH 4 N 2 S. Тиомочевина - белые ромбические кристаллы горького...

цену уточняйте
в наличии
Стандарт-титры
QazBioHim Industries
Алматы
Стандарт-титры Стандарт-титры, или фиксаналы - наборы химических реактивов, которые выпускаются в запаянных ампулах, содержащих точно известное количество вещества. Получение стандартного раствора точной концентрации про...
Рубрика:
Фиксаналы (стандарт-титры)

цену уточняйте
в наличии
Азотная кислота
КаzХимБаза
Алматы
Азотная кислота Основные характеристики азотной кислоты бесцветная жидкость с едким запахом, в высокой концентрации "дымится" на воздухе и приобретает бурый цвет на свету. HNO3 кристаллизуется при температуре +42 С, плав...

цену уточняйте
под заказ
Калибровочный раствор 470 мВ для ОВП метров в новой герметичной упаковке
LUXGROUP
Астана, Москва, Кокшетау
Область применения Калибровочные растворы или стандартные буферные растворы или рабочие эталоны предназначены для проверки и настройки точности измерения любых ОВП метров при измерении окислительно-восстановительного пот...
Рубрика:
Реактивные жидкости
цену уточняйте
под заказ
Кислотный тест
Теплофон
Темиртау, Караганда
Кислотный тест
Рубрика:
Реактивные жидкости
цену уточняйте
под заказ
Вода реагентная RTOCW для TOC (уп.35 мл)
Лаборфарма
Алматы, Астана
Вода реагентная RTOCW для TOC (уп.35 мл) Код товара 3260128
35 205 KZT
под заказ
Питательная среда №2 ГРМ Сабуро
QazBioHim Industries
Алматы
Питательная среда №2 ГРМ (Сабуро) Набор реагентов для контроля микробной загрязненности (для выращивания грибов) Питательная среда №2 (Сабуро) предназначена для выращивания и подсчета общего числа дрожжевых и плесневых г...
Рубрика:
Питательные среды

цену уточняйте
в наличии
Алюминий окись
КаzХимБаза
Алматы
Алюминий окись Оксид алюминия Al 2 O 3 — бинарное соединение алюминия и кислорода. В природе распространён как основная составляющая часть глинозёма, нестехиометрической смеси оксидов алюминия, калия, натрия, магния и т....

цену уточняйте
в наличии
Калибровочный раствор 240 мВ для ОВП метров в новой герметичной упаковке
LUXGROUP
Астана, Москва, Кокшетау
Область применения Калибровочные растворы или стандартные буферные растворы или рабочие эталоны предназначены для проверки и настройки точности измерения любых ОВП метров при измерении окислительно-восстановительного пот...
Рубрика:
Реактивные жидкости
цену уточняйте
под заказ
Тест-полоски на пищевые аллергены Rapid Test Easy
ЛабДепо
(Россия) Санкт-Петербург
Тест-полоски Rapid Test Easy - это самый простой набор для определения пищевого аллергена, который может обнаружить белки пищевого аллергена из образцов смывов с поверхности и промывных вод. Набор подходит для контроля з...
цену уточняйте
под заказ
Бензалконий хлористый стандартный образец (уп. 100 мг) LGC Standards
Лаборфарма
Алматы, Астана
Бензалконий хлористый стандартный образец (уп. 100 мг) LGC Standards Код товара 3360004

30 532 KZT
под заказ
Среда Бликфельдта-1
QazBioHim Industries
Алматы
Среда Бликфельдта-1 Среда Бликфельдта предназначена для выявления молочнокислых микроорганизмов в пищевых продуктах и кормах для животных (модификация 1 и модификация 2) и их подсчета (модификация 2), а также для выяснен...
Рубрика:
Питательные среды

цену уточняйте
в наличии
Алюмоаммонийные квасцы
КаzХимБаза
Алматы
Алюмоаммонийные квасцы Сульфат алюминия-аммония — неорганическое соединение, комплексная соль алюминия, аммония и серной кислоты с формулой NH 4 Al(SO 4 ) 2 , бесцветные кристаллы, растворяется в воде, образует кристалло...

цену уточняйте
в наличии
Калий хлористый KCl раствор 0.1 Моль для хранения электродов в новой герметичной упаковке
LUXGROUP
Астана, Москва, Кокшетау
Раствор калий хлористый (KCl) для хранения электродов Данный раствор позволяет существенно продлить срок службы рН и ОВП (ORP) электродов. Мы рекомендуем его приобретать даже с приборами у которых производителем предусмо...
Рубрика:
Реактивные жидкости
цену уточняйте
под заказ
Бензальдегид стандартный образец (р=1,05, уп.1 мл) LGC Standards
Лаборфарма
Алматы, Астана
Бензальдегид стандартный образец (р=1,05, уп.1 мл) LGC Standards Код товара 3360006

3 530 KZT
в наличии
Стандарт-титр Натрий углекислый 0,1Н
QazBioHim Industries
Алматы
Стандарт-титр Натрий углекислый 0,1Н Стандарт-титры представляют собой ампулы с химическими реактивами, необходимыми для приготовления титрованных (стандартных) растворов с заданным объемом и точной концентрацией, удобны...
Рубрика:
Фиксаналы (стандарт-титры)

цену уточняйте
в наличии
Аммиак водный
КаzХимБаза
Алматы
Аммиак водный Прозрачная бесцветная или желтоватая жидкость с резким запахом, хорошо растворяется в воде, спирте и в других органических растворителях Молекулярная масса: 17,03 г/моль. Плотность 0,907 г /см3.

цену уточняйте
в наличии
HR33 калибровочная соль 33% для влагомеров
LUXGROUP
Астана, Москва, Кокшетау
Соль с относительной влажностью 33% предназначена для калибровки влагомеров, имеющих такую функцию. Диаметр отверстия в банке для датчика 15мм. Производитель: AZ Instrument
Рубрика:
Реактивные жидкости
цену уточняйте
под заказ
Акрилонитрил, более 99% (p=0,8, уп.1л ) Sigma-Aldrich
Лаборфарма
Алматы, Астана
Акрилонитрил, более 99% (p=0,8, уп.1л ) Sigma-Aldrich Код товара 2682466

3 600 KZT
в наличии
Стандарт-титр Калий хлористый 0,1Н
QazBioHim Industries
Алматы
Стандарт-титр Калий хлористый 0,1Н Стандарт-титры представляют собой ампулы с химическими реактивами, необходимыми для приготовления титрованных (стандартных) растворов с заданным объемом и точной концентрацией, удобны п...
Рубрика:
Фиксаналы (стандарт-титры)

цену уточняйте
в наличии
Аммоний азотнокислый
КаzХимБаза
Алматы
Аммоний азотнокислый Аммиачная селитра - представляет собой кристаллический порошок или гранулы белого цвета с желтоватым оттенком, соль азотной кислоты. Хорошо растворяется в воде, аммиаке, пиридине, метаноле, этаноле. ...

цену уточняйте
под заказ
HR75 калибровочная соль 75% для влагомеров
LUXGROUP
Астана, Москва, Кокшетау
Соль с относительной влажностью 75% предназначена для калибровки влагомеров, имеющих такую функцию. Диаметр отверстия в банке для датчика 15мм. Производитель: AZ Instrument
Рубрика:
Реактивные жидкости
цену уточняйте
под заказ
Бензол-D6 99,6%, (уп.10x1мл) Sigma-Aldrich
Лаборфарма
Алматы, Астана
Бензол-D6 99,6%, (уп.10x1мл) Sigma-Aldrich Код товара 2682553

3 565 KZT
в наличии
Стандарт-титр Магний сернокислый 0,1Н
QazBioHim Industries
Алматы
Стандарт-титр Магний сернокислый 0,1Н Стандарт-титры представляют собой ампулы с химическими реактивами, необходимыми для приготовления титрованных (стандартных) растворов с заданным объемом и точной концентрацией, удобн...
Рубрика:
Фиксаналы (стандарт-титры)

цену уточняйте
в наличии
Барий азотнокислый
КаzХимБаза
Алматы
Барий азотнокислый Синонимы: Нитрат бария, барий азотнокислый, бариевая селитра, бариевая соль азотной кислоты Описание Нитрат бария (азотнокислый барий, бариевая селитра) — бариевая соль азотной кислоты, кристаллы белог...

цену уточняйте
в наличии
PH4 Порошок с реагентом для приготовления калибровочного раствора pH4.01
LUXGROUP
Астана, Москва, Кокшетау
С помощью данного реагента вы можете легко приготовить калибровочный раствор номиналом рН 4.0 в домашних условиях. Для приготовления раствора вам понадобится: одна упаковка реагента чистая стеклянная посуда 250 мл деониз...
Рубрика:
Реактивные жидкости
|
|
2009-2025 © All Rights Reserved
|